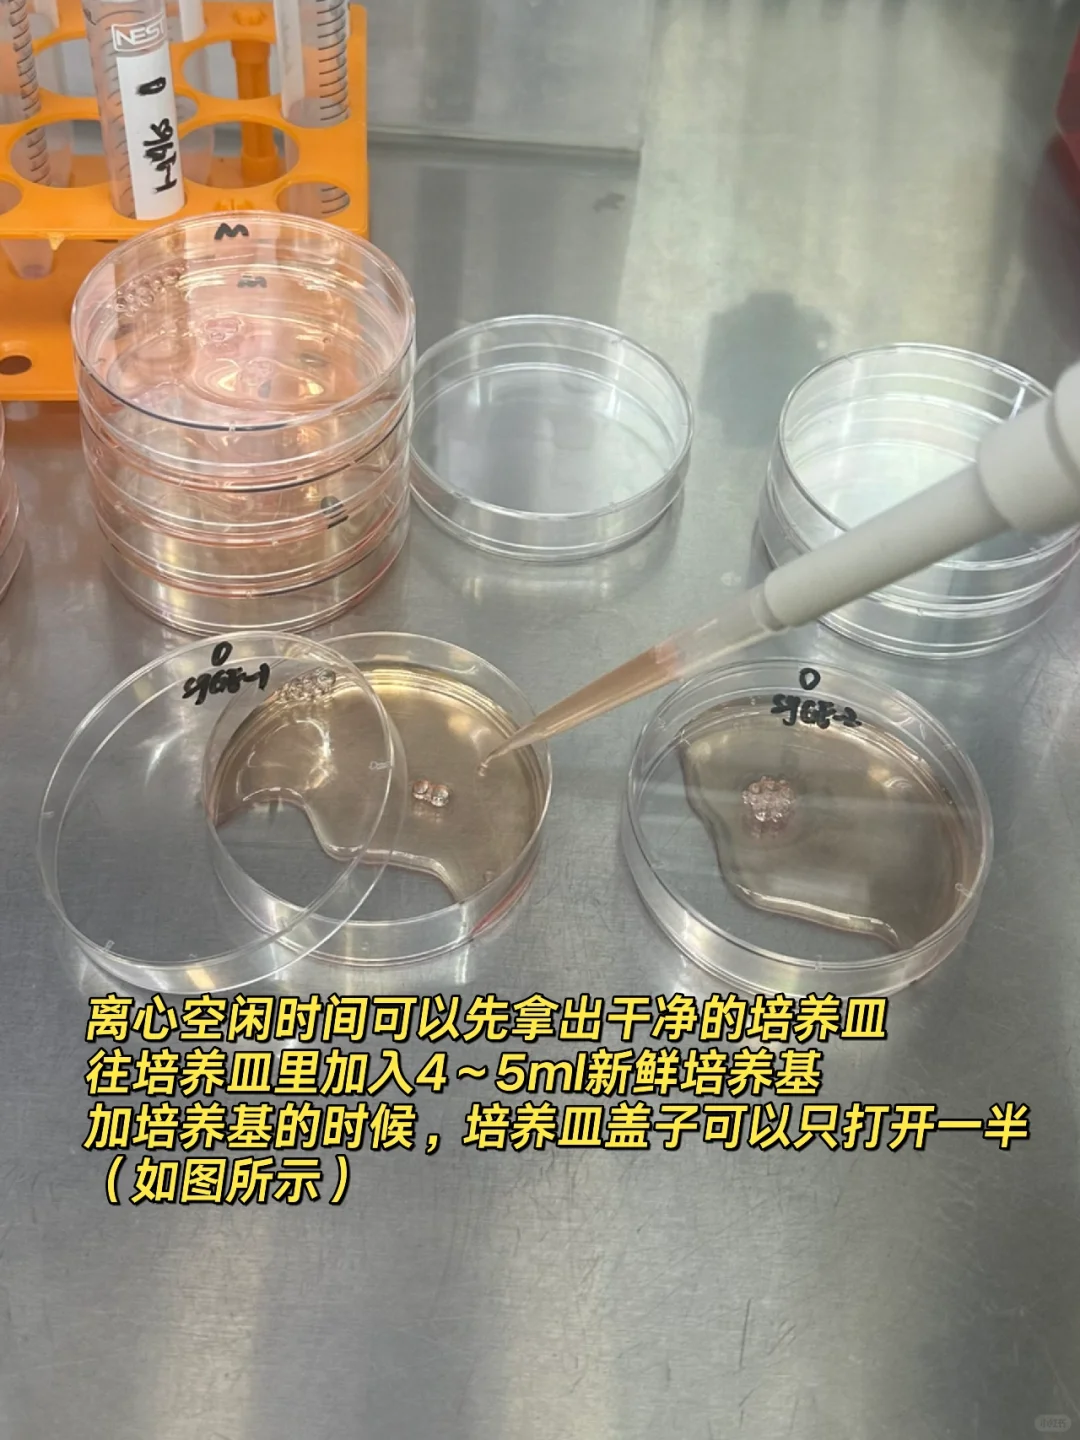

很多人都遇到一个问题是:细胞冻存的时候用状态很好的细胞冻的,但是复苏却复苏不起来,细胞死掉了这种情况,这其实和冻存手法,复苏细胞手法有很大的关系。
⚠️关于如何冻存细胞之前已发过笔记,大家可以自行翻阅,今天分享的是复苏细胞需要注意哪些问题。
✅正确复苏细胞手法:
1、复苏细胞的时候最好加个袋子,或者用飘子卡住冻存管进行复苏(如图所示),这样可以一定程度上保证细胞不污染。
2、不要直接把冻存管丢进水浴锅!!!这样容易污染!
3、37度水浴锅复苏,缓冻速溶法则。
4、往干净的离心管里加2~3ml培养基作为环境,再把细胞复苏后的液体加进去,这样缓冲一下,对细胞好。
5、刚复苏的细胞一定要低转速离心!400~500rpm都可,可以一定程度上去除掉因为冻存而死掉的细胞,使其更干净。
6、新复苏的细胞先不要加双抗!不要加双抗!不要加双抗!之后养起来看情况再加!
10%血清浓度,🧫培养基用的gibco,胎牛血清用的和元李记生物的特级胎牛血清。
之前胎牛血清我们组依科赛,普诺赛,全式金都用过,仅适用于部分细胞,一些比较难养的悬浮细胞使用感受并不好,gibco血清是可以养的不错但是奈何经费有限…[笑哭R]
最近新入了和元李记生物的特级胎牛血清,我之前很难养的一株悬浮细胞竟然长势特别好,真的让我很惊喜。[萌萌哒R]
如果大家的操作手法都没问题但依旧养不好的话,可以考虑换一个pai子的血清试试看,和元李记的特级胎牛血清我用着还不错。👍
👾个人使用感受:
之前使用的那些血清尤其是依科赛,养出来的悬浮细胞变形严重,本该是很圆润的细胞,养一段时间慢慢就伸触角,毛毛躁躁,做流式还分群。
换了和元李记血清,没有这种现象了,细胞一直都很圆润,并且长势飞快~我还检测了一下贴壁细胞的培养效果,细胞长势也是很好的。
除此之外,同时用gibco血清与和元李记血清培养同一株悬浮细胞看差别,二者长势类似,都没有变形情况。
🧫🧫🧫🧫经费有预算的宝子们真的可以尝试下和元李记家的血清,个人感觉是喜欢的。[派对R]